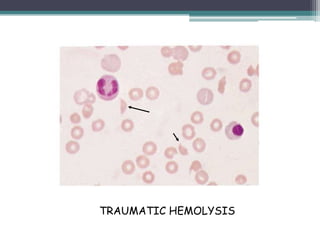
TRAUMATIC HEMOLYSIS
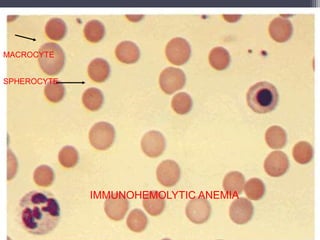
IMMUNOHEMOLYTIC ANEMIA
MACROCYTE
SPHEROCYTE
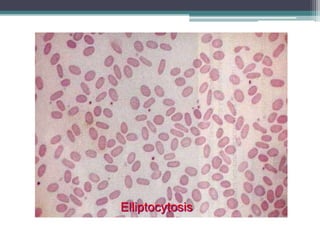
Elliptocytosis

This document discusses hemolytic anemia, which is a condition characterized by the premature destruction of red blood cells in the circulation. It defines hemolytic anemia as a reduced red blood cell lifespan. Some key points covered include:
- Causes of hemolytic anemia include genetic disorders like sickle cell anemia and thalassemia as well as acquired conditions like autoimmune hemolytic anemia.
- Signs and symptoms include fatigue, jaundice, and dark urine due to the breakdown of hemoglobin. Laboratory findings provide diagnostic clues like elevated bilirubin, reticulocytes, and lactate dehydrogenase.
- Different types of anemia are classified based on whether hemolysis